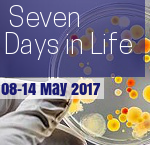
150

19 – 25 June 2017 A surprisingly simple explanation for the shape of bird eggs Now, for the first time, scientists have a convincing explanation for this stunning shape diversity in birds' eggs: The shape of a bird’s egg depends on how much its species flies. Find source US court grants Elsevier millions …
Category Archive: Uncategorized
Seven Days in Life
12 – 18 June 2017 Swipe right for science: Papr app is ‘Tinder for preprints’ Inspired by the dating app Tinder, which asks users to ‘swipe right’ across their screens to approve prospective matches, an app called Papr is inviting scientists to swipe to rate life-sciences preprints. Find source Computers are starting to reason …
Seven Days in Life
05 – 11 June 2017 Oldest Homo sapiens bones ever found shake foundations of the human story Idea that modern humans evolved in East Africa 200,000 years ago challenged by extraordinary discovery of 300,000-year-old remains in Moroccan mine. Find source New software tool could help doctors diagnose genetic diseases An open-source software tool called …
Seven Days in Life
29 May – 04 June 2017 Ultra-tough antibiotic to fight superbugs US scientists have re-engineered a vital antibiotic in a bid to wipe out one of the world's most threatening superbugs. Super-antibiotic is 25,000 times more potent than its predecessor. Find source Older mothers have higher rates of severe complications in childbirth The risk …
Seven Days in Life
22 – 28 May 2017 Monument to peer review unveiled in Moscow On 26 May students, researchers and Russia’s deputy minister of education and science — gathered outside Moscow’s Higher School of Economics (HSE) to witness the unveiling of what is probably the world's first monument to peer review. Find source NIH scales back …
May Issue Published; Vol 4(3)
New issue of ALS is now published. This time, in our multidisciplinary reads, we feature articles exploring mitochondrial DNA of Gujar clan in Pakistan; How Diabetes & HCV are aspects of the same problem; What bacteria degrade cypermethrin? Exploring Common patterns of AF & Metabolic syndrome and lastly how, in Iran, salinity is effecting medicinal …
Seven Days in Life
15 – 21 May 2017 UK political parties promise science funding boost Tim Farron (Liberal Democrat), Theresa May (Conservative), and Jeremy Corbyn (Labour) have all presented manifestos that pledge to raise UK R&D spending.The announcements came in party manifestos unveiled ahead of national elections in June. Find source Lab-grown blood stem cells produced at …
Seven Days in Life
08 – 14 May 2017 Ebola vaccine could get first real-world test in emerging outbreak An outbreak of the Ebola virus has emerged in the Democratic Republic of Congo (DRC), the World Health Organization (WHO) said on 12 May. Officials are considering to deploy an experimental Ebola vaccine against the outbreak. Find source …
Seven Days in Life
01 – 07 May 2017 Indian scientist forged ISIS letter to draw attention to his AIDS research An Indian scientist has been caught forging a threatening letter from ISIS and reporting a false attack. Mukesh Shukla faked the ISIS threats in an effort to publicize his research in Arabic, using Google Translate. Find source …
Seven Days in Life
24 – 30 April 2017 Another blow to science after Trump? Marine Le Pen is a ‘terrible danger,’ French research leaders say The French science community appears united against far-right candidate for president Marine Le Pen. Directors of nine major public research institutes describe Le Pen’s candidacy as a “terrible danger”. Find source Climate change is …